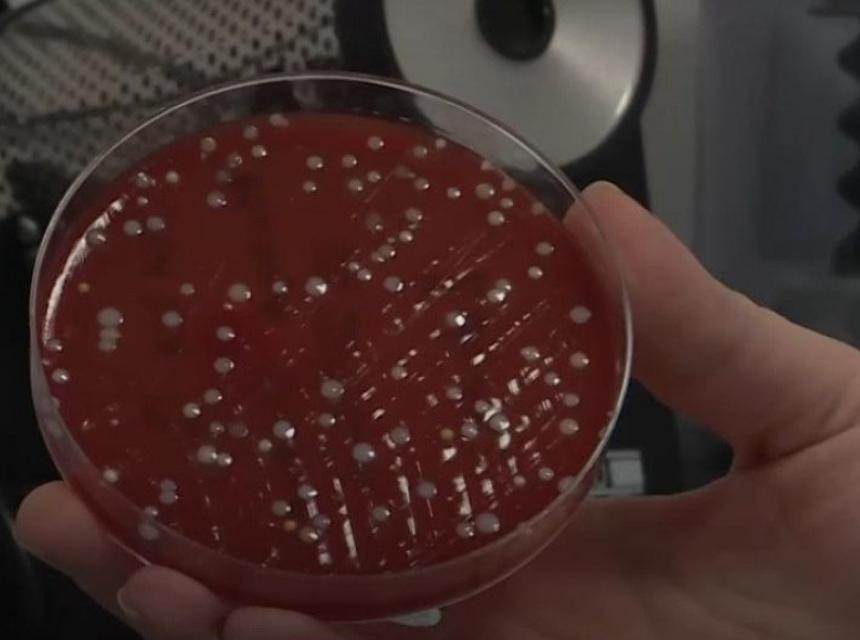

Zakon kaže gdje se moraju nositi zaštitne maske, ali ne kaže trebaju li biti čiste i koliko često se trebaju mijenjati.
Stavljamo ih u džep, u torbu, nosimo oko ruku, držimo ispod brade, ne razmišljajući utiče li to na njihovu učinkovitost.
Mikrobiološka laboratorija je provjerila šta sve živi na maskama koje su uzete od građana Sarajeva.
-Tu su neke bakterije koje se nalaze na rukama, ali, ako se u nekim drugim uvjetima nađu mogu biti patogene, mogu izazvati oboljenja, rečeno je iz Mikrobiološke laboratorije.
Svjetska zdravstvena organizacija preporučuje da se maske mijenjaju svaki dan, piše RSE.
Koliko građani Sarajeva, Beograda i Podgorice često mijenjaju maske i šta se nalazi na njima kod onih koji maske nose duže, pogledajte u prilogu:
Video možete pogledati i OVDJE